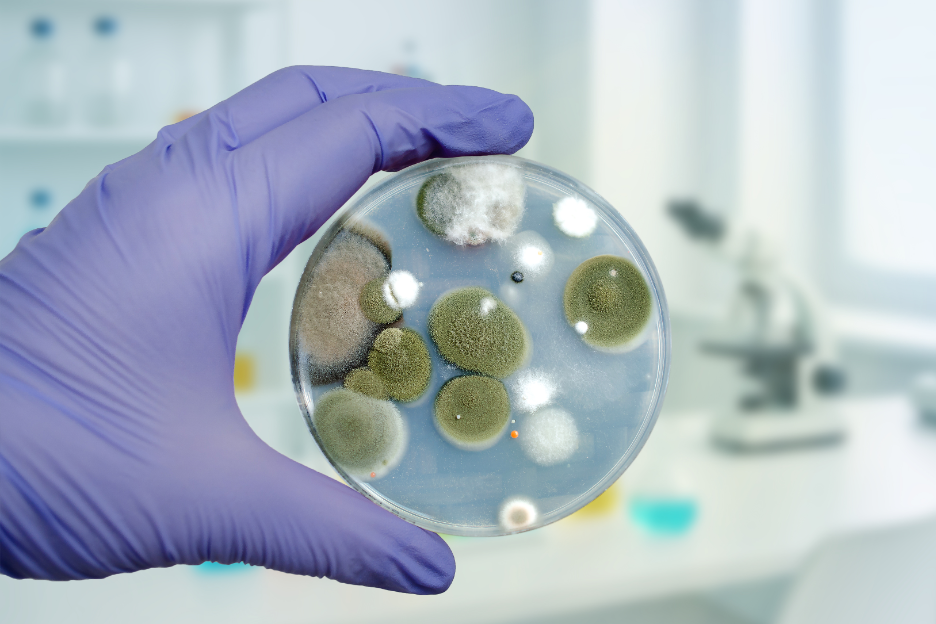
How Do Professionals Prevent Cross-Contamination During Mold Remediation? Insights from a Mold Removal Company in Evanston, Illinois

by Axis Response Group | Jan 24, 2026 | Asbestos
Asbestos is commonly found in many older industrial buildings, especially in facilities that were constructed before modern safety standards were established. When asbestos-containing materials (ACMs) remain intact and undisturbed, they are generally considered low...

by Axis Response Group | Jan 9, 2026 | Mold
Mold problems are rarely limited to only one visible area of a commercial property. Mold spreads through tiny airborne spores that can easily travel from room to room. If technicians do not handle remediation correctly, those spores can settle in clean areas and cause...

Recent Comments